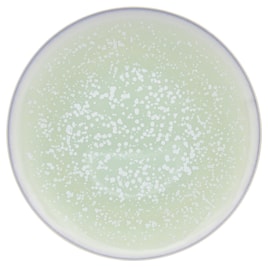
Jaune de Chrome, Song Amande, Gourmet plate
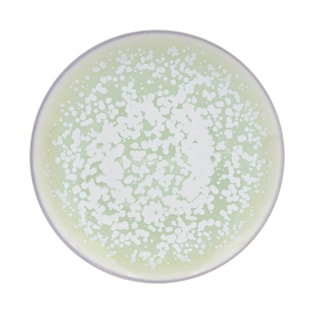
Jaune de Chrome, Song Amande, Dessert plate

Song Amande
Savor the revitalizing aura of a gentle zephyr with Jaune de Chrome's Song Amande dinnerware collection. Demonstrating unparalleled mastery over glazing techniques, Jaune de Chrome enhances the distinguished Limoges porcelain from their associated brand, J.L Coquet, with this extraordinary collection. The dynamic, elegant, and truly captivating dinnerware is sure to surprise and delight your guests with its spellbinding glazing craftsmanship.
In a departure from standard printing or painting techniques, Jaune de Chrome's artisans adeptly apply pigmented glazes to the raw porcelain via spray painting, which is then diligently fired to achieve a perfect finish. The décor integrates seamlessly with the glaze, giving rise to surfaces that are impeccably glossy, smooth, and resistant to scratches. This innovative process guarantees that the dinnerware is not only visually stunning but also incredibly easy to upkeep.
The Song Amande china collection features a thoughtfully chosen assortment of popular shapes from J.L Coquet. The collection's glaze incorporates metallic pigments, adding an extra layer of luxury to the collection.